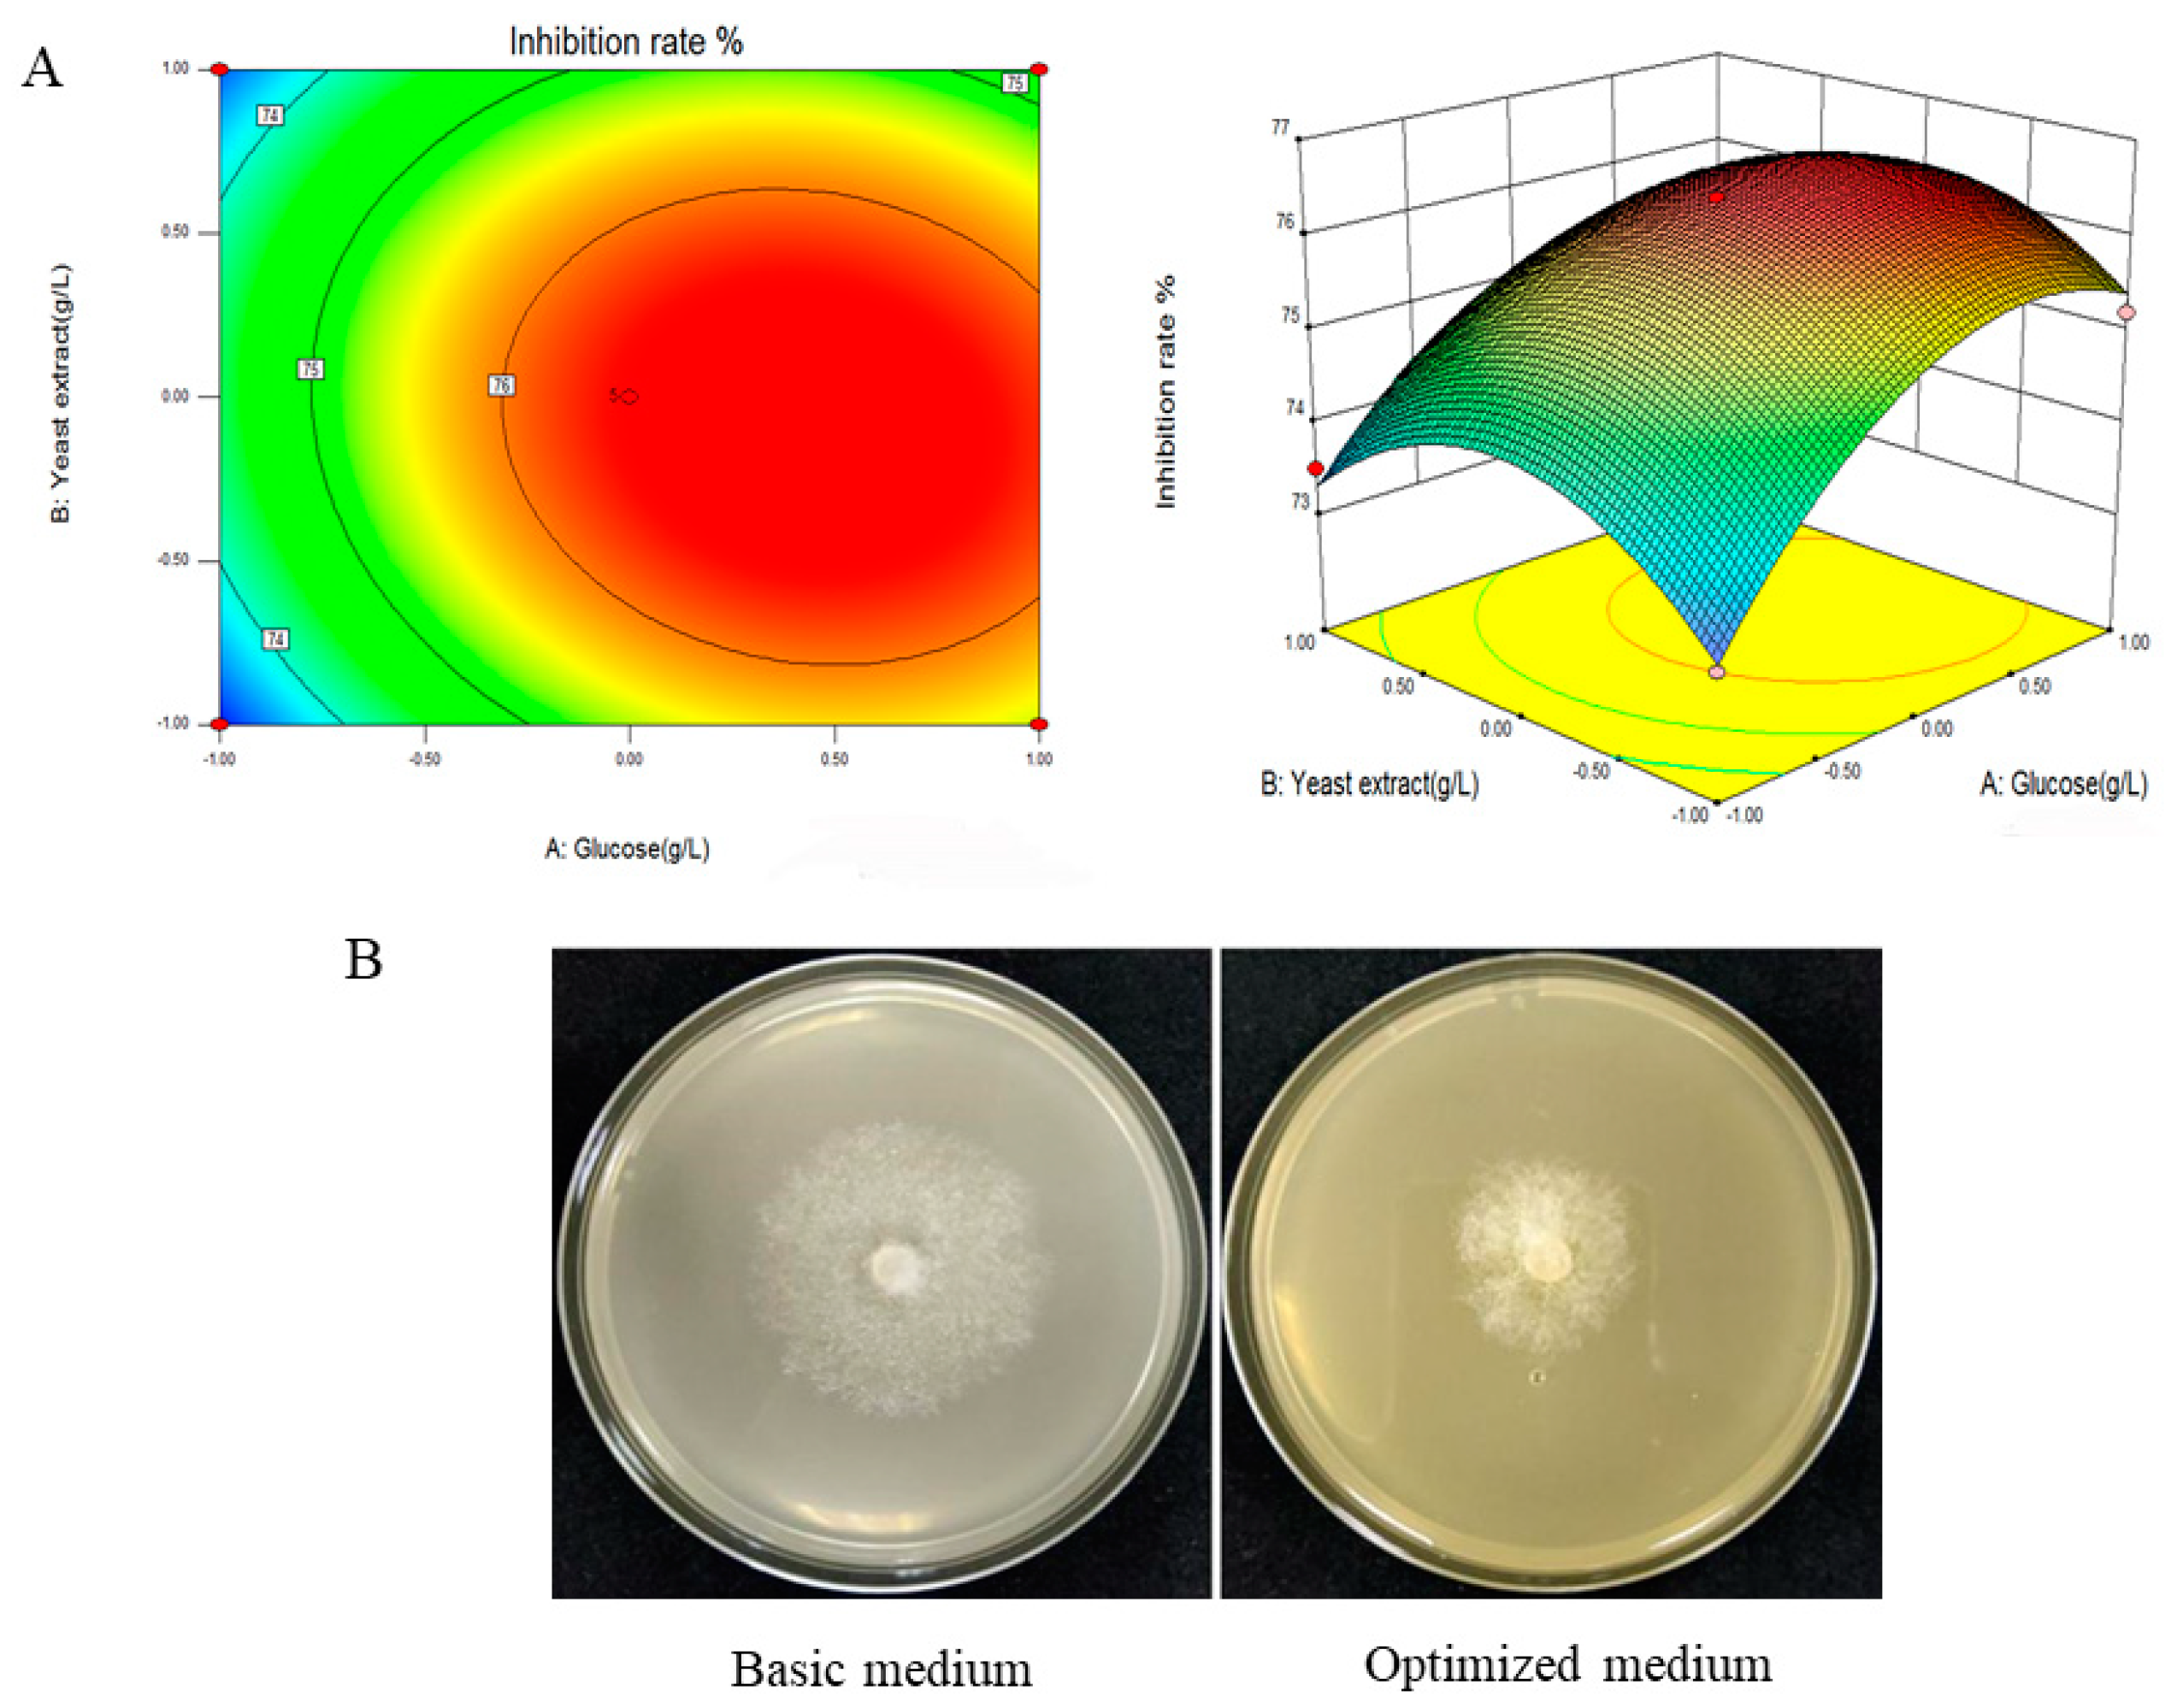
Fermentation 10 00021 g002

Optimization of Pseudomonas aurantiaca ST-TJ4 Fermentation Medium and Its Control Effect on Phytophthora cinnamomi
Abstract
:1. Introduction
2. Materials and Methods
2.1. Bacterial and Fungal Strains
2.2. Preparation of Fermentation Filtrate and Determination of Antagonistic Activity
2.3. Optimization of Fermentation Medium Components by Single-Factor Experiments
2.4. Screening Significant Fermentation Medium Components via the Plackett–Burman Design
2.5. Path of Steepest Ascent Method Test
2.6. Box–Behnken Design Central Combination Test
2.7. RNA Extraction and RT-qPCR Analysis
2.8. Stability of the Active Metabolites in the Fermentation Filtrate
2.9. Pathogenicity Assays on Detached Leaves of Rhododendron pulchrum
2.10. Detection of the Colonization of P. cinnamomi in Plant Leaves
2.11. Statistical Analysis
3. Results
3.1. Single-Factor Screening Test
3.2. Plackett–Burman Design Test
3.3. Path of Steepest Ascent Method Test
3.4. Optimizing Significant Fermentation Parameters via Box–Behnken Design
3.5. P. aurantiaca ST-TJ4 Phenazine-Related Gene Expression Analysis
3.6. Stability of Fermentation Filtrate from ST-TJ4
3.7. Control Effect of ST-TJ4 on R. pulchrum Spot Disease Caused by P. cinnamomi
4. Discussion
5. Conclusions
Supplementary Materials
Author Contributions
Funding
Data Availability Statement
Conflicts of Interest
References
- Santoyo, G.; Orozco-Mosqueda, M.D.; Govindappa, M. Mechanisms of biocontrol and plant growth-promoting activity in soil bacterial species of a Bacillus and Pseudomonas: A review. Biocontrol Sci. Technol. 2012, 22, 855–872. [Google Scholar] [CrossRef]
- Ni, H.; Kong, W.-L.; Zhang, Y.; Wu, X.-Q. Effects of Volatile Organic Compounds Produced by Pseudomonas aurantiaca ST-TJ4 against Verticillium dahliae. J. Fungi 2022, 8, 697. [Google Scholar] [CrossRef] [PubMed]
- Mavrodi, O.V.; Walter, N.; Elateek, S.; Taylor, C.G.; Okubara, P.A. Suppression of Rhizoctonia and Pythium root rot of wheat by new strains of Pseudomonas. Biol. Control 2012, 62, 93–102. [Google Scholar] [CrossRef]
- Raaijmakers, J.M.; De Bruijn, I.; De Kock, M.J. Cyclic Lipopeptide Production by Plant-Associated Pseudomonas spp.: Diversity, Activity, Biosynthesis, and Regulation. Mol. Plant-Microbe Interact. 2006, 19, 699–710. [Google Scholar] [CrossRef] [PubMed]
- Almario, J.; Bruto, M.; Vacheron, J.; Prigent-Combaret, C.; Moenne-Loccoz, Y.; Muller, D. Distribution of 2,4-Diacetylphloroglucinol Biosynthetic Genes among the Pseudomonas spp. Reveals Unexpected Polyphyletism. Front. Microbiol. 2017, 8, 1218. [Google Scholar] [CrossRef]
- Peix, A.; Valverde, A.; Rivas, R.; Igual, J.M.; Ramirez-Bahena, M.H.; Mateos, P.F.; Santa-Regina, I.; Rodriguez-Barrueco, C.; Martinez-Molina, E.; Velazquez, E. Reclassification of Pseudomonas aurantiaca as a synonym of Pseudomonas chlororaphis and proposal of three subspecies, P. chlororaphis subsp. chlororaphis subsp. nov., P. chlororaphis subsp. aureofaciens subsp. nov., comb. nov. and P. chlororaphis subsp. aurantiaca subsp. nov., comb. nov. Int. J. Syst. Evol. Microbiol. 2007, 57, 1286–1290. [Google Scholar] [PubMed]
- Shi, Y.; Zaleta-Pinet, D.A.; Clark, B.R. Isolation, Identification, and Decomposition of Antibacterial Dialkylresorcinols from a Chinese Pseudomonas aurantiaca Strain. J. Nat. Prod. 2020, 83, 194–201. [Google Scholar] [CrossRef]
- Shahid, I.; Han, J.; Hardie, D.; Baig, D.N.; Malik, K.A.; Borchers, C.H.; Mehnaz, S. Profiling of antimicrobial metabolites of plant growth promoting Pseudomonas spp. isolated from different plant hosts. 3 Biotech 2021, 11, 48. [Google Scholar]
- Tagele, S.B.; Lee, H.G.; Kim, S.W.; Lee, Y.S. Phenazine and 1-Undecene Producing Pseudomonas chlororaphis subsp. aurantiaca Strain KNU17Pc1 for Growth Promotion and Disease Suppression in Korean Maize Cultivars. J. Microbiol. Biotechnol. 2019, 29, 66–78. [Google Scholar] [CrossRef]
- Hu, W.Q.; Gao, Q.X.; Hamada, M.S.; Dawood, D.H.; Zheng, J.W.; Chen, Y.; Ma, Z.H. Potential of Pseudomonas chlororaphis subsp. aurantiaca Strain Pcho10 as a Biocontrol Agent against Fusarium graminearum. Phytopathology 2014, 104, 1289–1297. [Google Scholar] [CrossRef]
- Lazazzara, V.; Perazzolli, M.; Pertot, I.; Biasioli, F.; Puopolo, G.; Cappellin, L. Growth media affect the volatilome and antimicrobial activity against Phytophthora infestans in four Lysobacter type strains. Microbiol. Res. 2017, 201, 52–62. [Google Scholar] [CrossRef] [PubMed]
- Liu, Q.; Yang, J.; Wang, X.; Wei, L.; Ji, G. Effect of culture medium optimization on the secondary metabolite activity of Lysobacter antibioticus 13-6. Prep. Biochem. Biotechnol. 2021, 51, 1008–1017. [Google Scholar] [CrossRef] [PubMed]
- Dai, Y.; Wang, Y.H.; Li, M.; Zhu, M.L.; Wen, T.Y.; Wu, X.Q. Medium optimization to analyze the protein composition of Bacillus pumilus HR10 antagonizing Sphaeropsis sapinea. AMB Express 2022, 12, 61. [Google Scholar] [CrossRef] [PubMed]
- Zhang, S.W.; Gan, Y.T.; Liu, J.; Zhou, J.J.; Xu, B.L. Optimization of the Fermentation Media and Parameters for the Bio-control Potential of Trichoderma longibrachiatum T6 Against Nematodes. Front. Microbiol. 2020, 11, 574601. [Google Scholar] [CrossRef] [PubMed]
- Zhou, Y.; Wang, J.Y.; Gao, X.J.; Wang, K.; Wang, W.W.; Wang, Q.; Yan, P.S. Isolation of a novel deep-sea Bacillus circulus strain and uniform design for optimization of its anti-aflatoxigenic bioactive metabolites production. Bioengineered 2019, 10, 13–22. [Google Scholar] [CrossRef] [PubMed]
- Yan, L.; Zhang, Z.; Zhang, Y.; Yang, H.; Qiu, G.; Wang, D.; Lian, Y. Improvement of tacrolimus production in Streptomyces tsukubaensis by mutagenesis and optimization of fermentation medium using Plackett-Burman design combined with response surface methodology. Biotechnol. Lett. 2021, 43, 1765–1778. [Google Scholar] [CrossRef]
- Shafi, J.; Sun, Z.; Ji, M.; Gu, Z.; Ahmad, W. ANN and RSM based modelling for optimization of cell dry mass of Bacillus sp. strain B67 and its antifungal activity against Botrytis cinerea. Biotechnol. Biotechnol. Equip. 2017, 32, 58–68. [Google Scholar] [CrossRef]
- Latha, S.; Sivaranjani, G.; Dhanasekaran, D. Response surface methodology: A non-conventional statistical tool to maximize the throughput of Streptomyces species biomass and their bioactive metabolites. Crit. Rev. Microbiol. 2017, 43, 567–582. [Google Scholar] [CrossRef]
- Yun, T.Y.; Feng, R.J.; Zhou, D.B.; Pan, Y.Y.; Chen, Y.F.; Wang, F.; Yin, L.Y.; Zhang, Y.D.; Xie, J.H. Optimization of fermentation conditions through response surface methodology for enhanced antibacterial metabolite production by Streptomyces sp. 1–14 from cassava rhizosphere. PLoS ONE 2018, 13, e0206497. [Google Scholar] [CrossRef]
- Pan, M.; Wang, Y.R.; Tan, J.J.; Liu, F.; Hu, J.F. Optimization of Fermentation Conditions for Bacillus pumilus LYMC-3 to Antagonize Sphaeropsis sapinea. Fermentation 2023, 9, 482. [Google Scholar] [CrossRef]
- Zhang, Y.; Kong, W.L.; Wu, X.Q.; Li, P.S. Inhibitory effects of phenazine compounds and VOCs produced by Pseudomonas aurantiaca ST-TJ4 against Phytophthora cinnamomi. Phytopathology 2022, 112, 1867–1876. [Google Scholar] [CrossRef] [PubMed]
- Kong, W.L.; Li, P.S.; Wu, X.Q.; Wu, T.Y.; Sun, X.R. Forest Tree Associated Bacterial Diffusible and Volatile Organic Compounds against Various Phytopathogenic Fungi. Microorganisms 2020, 8, 590. [Google Scholar] [CrossRef] [PubMed]
- Zhu, M.L.; Wu, X.Q.; Wang, Y.H.; Dai, Y. Role of Biofilm Formation by Bacillus pumilus HR10 in Biocontrol against Pine Seedling Damping-Off Disease Caused by Rhizoctonia solani. Forests 2020, 11, 652. [Google Scholar] [CrossRef]
- Dai, Y.; Wu, X.Q.; Wang, Y.H.; Zhu, M.L. Biocontrol potential of Bacillus pumilus HR10 against Sphaeropsis shoot blight disease of pine. Biol. Control 2021, 152, 104458. [Google Scholar] [CrossRef]
- Husseiny, S.M.; Abdelhafez, A.A.; Ali, A.A.; Sand, H.M. Optimization of β-Carotene Production from Rhodotorula glutinis ATCC 4054 Growing on Agro-industrial Substrate Using Plackett–Burman Design. Proc. Natl. Acad. Sci. India Sect. B Biol. Sci. 2018, 88, 1637–1646. [Google Scholar] [CrossRef]
- Zalila-Kolsi, I.; Kessentini, S.; Tounsi, S.; Jamoussi, K. Optimization of Bacillus amyloliquefaciens BLB369 Culture Medium by Response Surface Methodology for Low Cost Production of Antifungal Activity. Microorganisms 2022, 10, 830. [Google Scholar] [CrossRef] [PubMed]
- Chen, Z.P.; Jiao, B.B.; Zhou, J.; He, H.B.; Dai, T.T. Rapid detection of Phytophthora cinnamomi based on a new target gene Pcinn13739. Front. Cell. Infect. Microbiol. 2022, 12, 923700. [Google Scholar] [CrossRef]
- Zhang, L.; Cai, Y.; Zhang, M.; Du, G.; Wang, J. Selection and Evaluation of Candidate Reference Genes for Quantitative Real-Time PCR in Aboveground Tissues and Drought Conditions in Rhododendron delavayi. Front. Genet. 2022, 13, 876482. [Google Scholar] [CrossRef]
- Sah, S.; Krishnani, S.; Singh, R. Pseudomonas mediated nutritional and growth promotional activities for sustainable food security. Curr. Res. Microb. Sci. 2021, 2, 100084. [Google Scholar] [CrossRef]
- Zhang, Q.X.; Stummer, B.E.; Guo, Q.Q.; Zhang, W.; Zhang, X.J.; Harvey Paul, R. Quantification of Pseudomonas protegens FD6 and Bacillus subtilis NCD-2 in soil and the wheat rhizosphere and suppression of root pathogenic Rhizoctonia solani AG-8. Biol. Control 2021, 154, 104504. [Google Scholar] [CrossRef]
- Mazurier, S.; Corberand, T.; Lemanceau, P.; Raaijmakers, J.M. Phenazine antibiotics produced by fluorescent pseudomonads contribute to natural soil suppressiveness to Fusarium wilt. ISME J. 2009, 3, 977–991. [Google Scholar] [CrossRef] [PubMed]
- Wan, Y.P.; Liu, H.C.; Xian, M.; Huang, W. Biosynthetic Pathway Construction and Production Enhancement of 1-Hydroxyphenazine Derivatives in Pseudomonas chlororaphis H18. J. Agric. Food Chem. 2022, 70, 1223–1231. [Google Scholar] [CrossRef] [PubMed]
- Zhang, Y.; Zhang, B.; Wu, X.G.; Zhang, L.Q. Effect of carbon sources on production of 2,4-diacetylphoroglucinol in Pseudomonas fluorescens 2P24. Acta Microbiol. Sin. 2018, 28, 1202–1212. [Google Scholar]
- Yue, S.J.; Huang, P.; Li, S.; Jan Malik Hu, H.B.; Wang, W.; Zhang, X.H. Enhanced Production of 2-Hydroxyphenazine from Glycerol by a Two-Stage Fermentation Strategy in Pseudomonas chlororaphis GP72AN. J. Agric. Food Chem. 2020, 68, 561–566. [Google Scholar] [CrossRef]
- Yu, L.; Jing, A.; Li, Y.; Gao, X.M.; Liu, X.H. Optimization of Fluid Medium and Stability of Sterile Fermentation Fluid of Bacillus amyloliticus DF-7. Shandong Agric. Sci. 2021, 53, 149–154. [Google Scholar]
- Li, M.T.; Tang, H.; Li, Z.Y.; Song, Y.; Chen, L.; Ran, C.; Jiang, Y.; Chen, C.Q. Optimization of the Production and Characterization of an Antifungal Protein by Bacillus velezensis Strain NT35 and Its Antifungal Activity against Ilyonectria robusta Causing Ginseng Rusty Root Rot. Fermentation 2023, 9, 358. [Google Scholar] [CrossRef]

| Factor | Levels | |
|---|---|---|
| −1 | 1 | |
| A glucose (g/L) | 10 | 15 |
| B glycerol (g/L) | 5 | 10 |
| C blank | ||
| D yeast extract (g/L) | 10 | 15 |
| E peptone (g/L) | 5 | 10 |
| F blank | ||
| G MgSO4∙7H2O (g/L) | 1.5 | 2 |
| H K2HPO4 (g/L) | 1.5 | 2 |
| Run | A | B | (C) | D | E | (F) | G | H | Inhibition Rate % |
|---|---|---|---|---|---|---|---|---|---|
| 1 | 1 | 1 | −1 | 1 | 1 | 1 | −1 | −1 | 75.3 |
| 2 | −1 | −1 | −1 | −1 | −1 | −1 | −1 | −1 | 63.5 |
| 3 | 1 | 1 | −1 | −1 | −1 | 1 | −1 | 1 | 72.3 |
| 4 | −1 | 1 | 1 | −1 | 1 | 1 | 1 | −1 | 67.2 |
| 5 | 1 | 1 | 1 | −1 | −1 | −1 | 1 | −1 | 70.2 |
| 6 | 1 | −1 | 1 | 1 | 1 | −1 | −1 | −1 | 74.5 |
| 7 | −1 | −1 | 1 | −1 | 1 | 1 | −1 | 1 | 64.6 |
| 8 | −1 | −1 | −1 | 1 | −1 | 1 | 1 | −1 | 68.8 |
| 9 | 1 | −1 | 1 | 1 | −1 | 1 | 1 | 1 | 75.1 |
| 10 | −1 | 1 | 1 | 1 | −1 | −1 | −1 | 1 | 68.8 |
| 11 | 1 | −1 | −1 | −1 | 1 | −1 | 1 | 1 | 70.6 |
| 12 | −1 | 1 | −1 | 1 | 1 | −1 | 1 | 1 | 68.0 |
| Factors | Coefficient | F-Value | p-Value | Significance |
|---|---|---|---|---|
| A Glucose (g/L) | 3.01 | 120.85 | 0.0016 | 1 |
| B Glycerin (g/L) | 0.48 | 3.01 | 0.1810 | 3 |
| D Yeast extract (g/L) | 1.93 | 49.48 | 0.0059 | 2 |
| E Peptone (g/L) | 0.21 | 0.58 | 0.5018 | 4 |
| G MgSO4 (g/L) | 0.16 | 0.33 | 0.6034 | 5 |
| H K2HPO4 (g/L) | 0.08 | 0.08 | 0.8018 | 6 |
| Run | Glucose (g/L) | Yeast Extract (g/L) | Inhibition Rate % |
|---|---|---|---|
| 1 | 10 | 10 | 60.8 |
| 2 | 13 | 12 | 65.5 |
| 3 | 16 | 14 | 73.2 |
| 4 | 19 | 16 | 76.5 |
| 5 | 22 | 18 | 74.8 |
| Run | Glucose (g/L) | Yeast Extract (g/L) | Inhibition Rate % |
|---|---|---|---|
| 1 | −1 | 1 | 73.5 |
| 2 | 1 | −1 | 75.2 |
| 3 | −1 | 0 | 73.8 |
| 4 | 0 | 1 | 74.5 |
| 5 | 1 | 0 | 75.8 |
| 6 | 1 | 1 | 74.8 |
| 7 | −1 | −1 | 73.0 |
| 8 | 0 | 0 | 76.4 |
| 9 | 0 | −1 | 75.0 |
| Source | Explained Sum of Squares | DF | Mean Square | F-Value | p-Value |
|---|---|---|---|---|---|
| Model | 10.96 | 5 | 2.19 | 18.12 | 0.0015 |
| A- Glucose | 7.03 | 1 | 7.03 | 58.13 | 0.0003 |
| B- Yeast extract | 0.086 | 1 | 0.01 | 0.71 | 0.4323 |
| AB | 0.20 | 1 | 0.20 | 1.67 | 0.2433 |
| A2 | 2.02 | 1 | 2.02 | 16.67 | 0.0065 |
| B2 | 2.49 | 1 | 2.49 | 20.60 | 0.0039 |
| Residual error | 0.73 | 6 | 0.12 | ||
| Lack of fit | 0.73 | 3 | 0.24 | ||
| Pure error | 0.00 | 3 | 0.00 | ||
| Cor total | 11.68 | 11 |
Disclaimer/Publisher’s Note: The statements, opinions and data contained in all publications are solely those of the individual author(s) and contributor(s) and not of MDPI and/or the editor(s). MDPI and/or the editor(s) disclaim responsibility for any injury to people or property resulting from any ideas, methods, instructions or products referred to in the content. |
© 2023 by the authors. Licensee MDPI, Basel, Switzerland. This article is an open access article distributed under the terms and conditions of the Creative Commons Attribution (CC BY) license (https://creativecommons.org/licenses/by/4.0/).
Share and Cite
Kong, W.-L.; Zhang, Y.; Wu, X.-Q. Optimization of Pseudomonas aurantiaca ST-TJ4 Fermentation Medium and Its Control Effect on Phytophthora cinnamomi. Fermentation 2024, 10, 21. https://doi.org/10.3390/fermentation10010021
Kong W-L, Zhang Y, Wu X-Q. Optimization of Pseudomonas aurantiaca ST-TJ4 Fermentation Medium and Its Control Effect on Phytophthora cinnamomi. Fermentation. 2024; 10(1):21. https://doi.org/10.3390/fermentation10010021
Chicago/Turabian StyleKong, Wei-Liang, Yu Zhang, and Xiao-Qin Wu. 2024. "Optimization of Pseudomonas aurantiaca ST-TJ4 Fermentation Medium and Its Control Effect on Phytophthora cinnamomi" Fermentation 10, no. 1: 21. https://doi.org/10.3390/fermentation10010021
APA StyleKong, W.-L., Zhang, Y., & Wu, X.-Q. (2024). Optimization of Pseudomonas aurantiaca ST-TJ4 Fermentation Medium and Its Control Effect on Phytophthora cinnamomi. Fermentation, 10(1), 21. https://doi.org/10.3390/fermentation10010021

